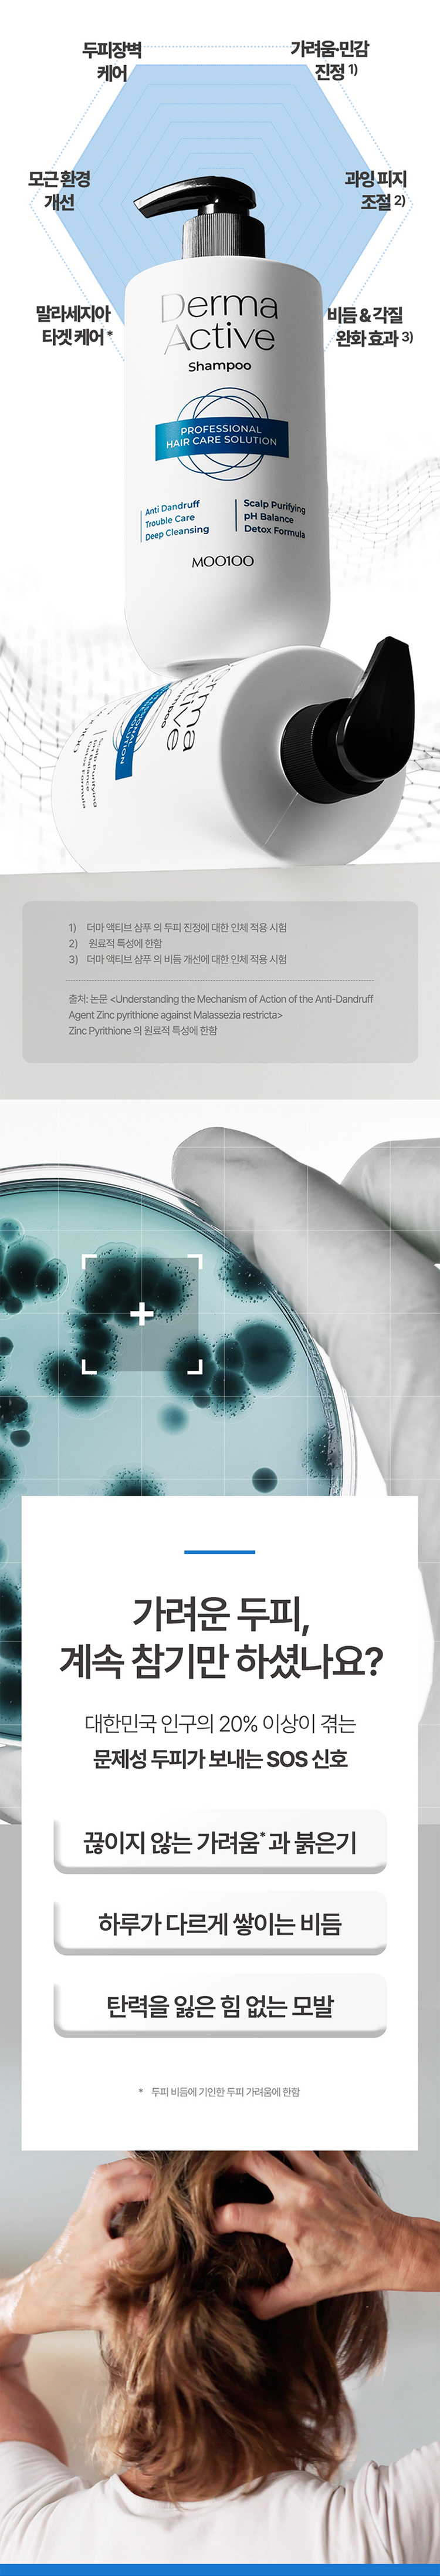

무백브랜드관
[비듬케어/진정] 무백 더마액티브 샴푸 500ml
10%
36,000
32,400
할인내역정보
- 판매가
- 36,000원
- 상품 할인
- - 3,600원
- 최적가
- 32,400원
- 할인기간 :2025.10.01~2025.10.31
- 기간은 사정에 의해 변경될 수 있습니다.
CHICOR 최대 적립 포인트
324
P
신세계 최대 적립 포인트
32
P
카드혜택
배송정보
시코르배송
2,500원
(30,000원 이상 구매시 무료배송 도서산간지역 4,500원)
구매수량
특별 할인 상품
닫기
결제금액 0원 이상 고객님께 1개의 상품을
특별할인가로 구매할 수 있는 혜택을 드립니다.
- 특별 할인 대상 상품의 단독 교환/반품은 불가합니다.
- 특별 할인 대상 상품과 함께 구매한 전체 상품의 반품 진행시 함께 반품해야 합니다.
- 특별 할인 대상 상품 포함하여 배송 전 전체 주문 취소 시에만 해당 이벤트에 재참여가 가능합니다. (해당 이벤트가 진행 중인 경우에 한함)
- 첫 구매 회원 대상 특별 할인의 경우, 첫 주문 건의 반품/교환시에는 해당 이벤트 재참여가 불가합니다.
- 특별 할인 대상 상품에 대해 시코르 귀책 사유 발생시 교환이 가능하며, ‘고객센터 > 1:1문의’로 접수바랍니다.
- 특별 할인 대상 상품은 당사 사정에 따라 조기 종료 및 변경될 수 있습니다.

※ 해당 상품 정보(상품 상세 설명)는 브랜드 본사 정책에 따라 협력사가 직접 등록한 것입니다.
상품 정보 및 A/S문의는 상품정보 제공고시를 참조해주시기 바랍니다.
리뷰 작성하기
닫기카드사혜택
닫기쿠폰 다운로드
원하시는 쿠폰을 선택해 주세요.
- 쿠폰 다운로드 후 사용기간 내 미사용시 재발급 되지 않습니다.
- 쿠폰 행사 일정은 당사 사정에 따라 변경/중단 될 수 있습니다.
- 대상 회원만 발급 가능 합니다.